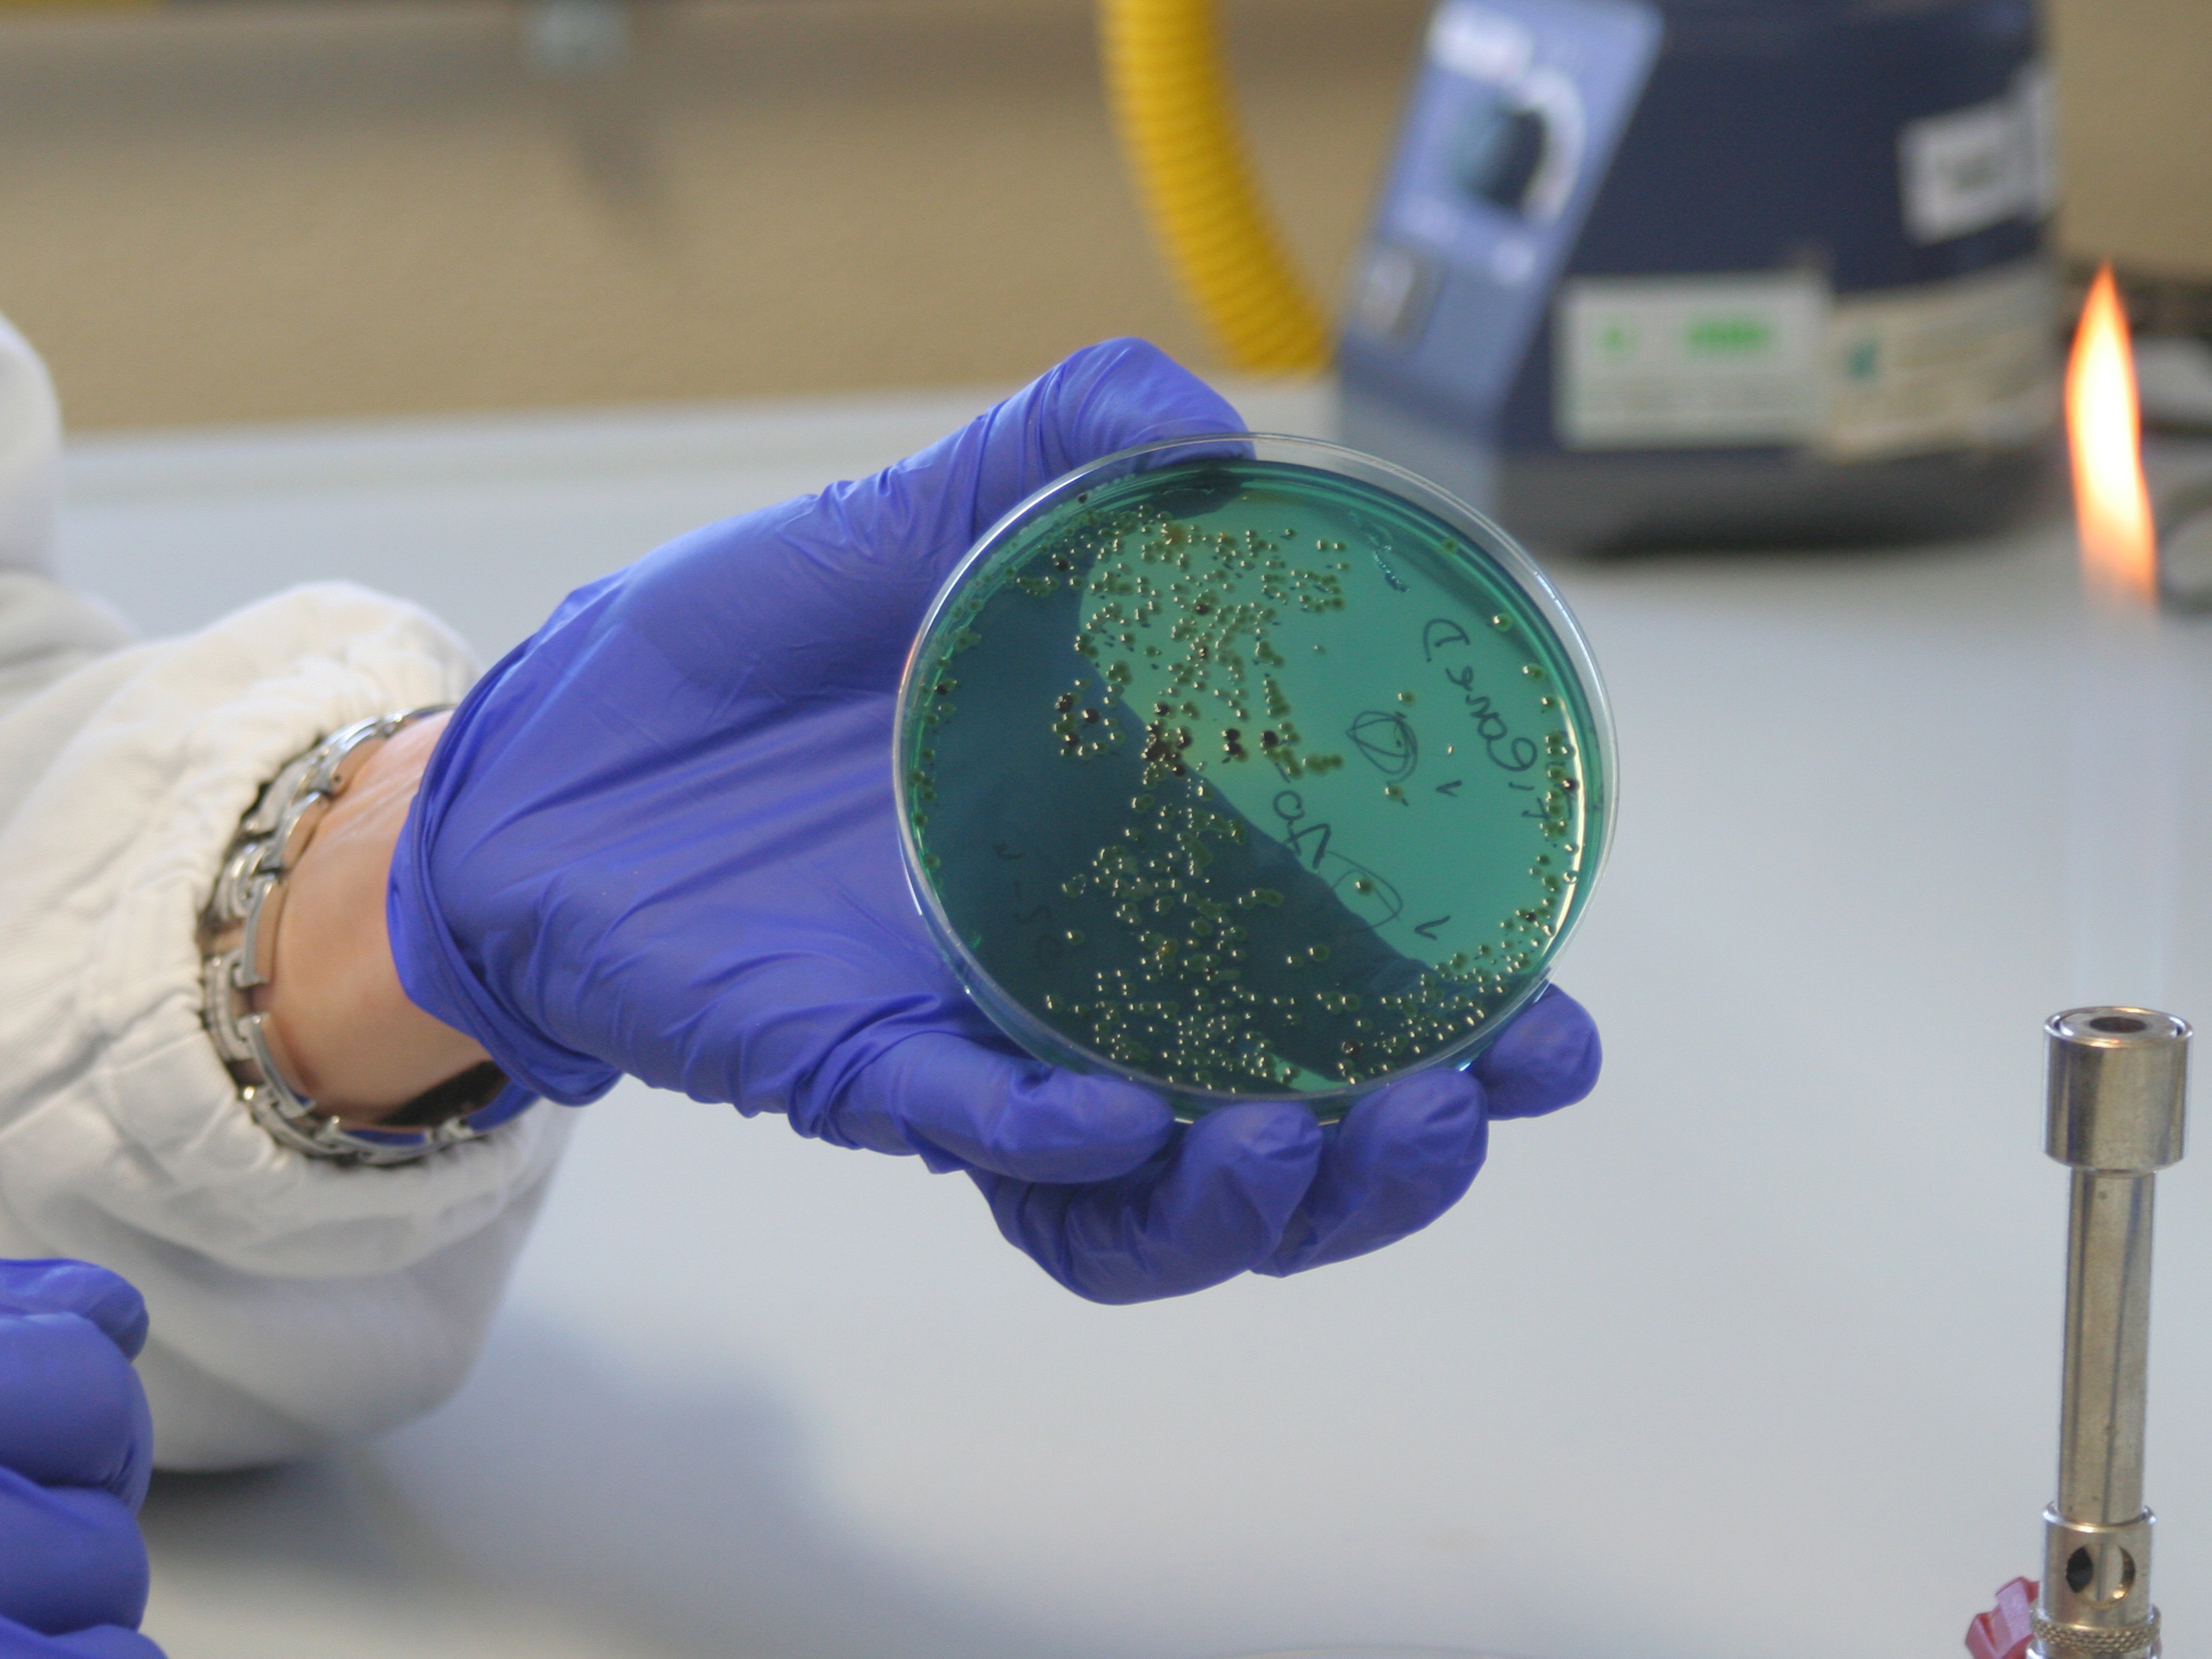
Chiocciola

Helix Recovery
Recupero della sostanza mucosa di scarto da allevamenti di chiocciole
Il Progetto
La conoscenza delle proprietà intrinseche del secreto mucoso della chiocciola, il recupero di una sostanza di scarto, la certificazione: questa è l’innovazione di HelixREC. Trovare un prodotto che risponda alle esigenze di mercato e sia in grado di crearne di nuovi.
Il progetto permetterà di valutare contemporaneamente diverse variabili: specie, habitat, tipologia di alimentazione, modalità di estrazione del secreto mucoso proveniente da chiocciole di allevamenti ubicati nella Regione Sardegna.
Il secreto mucoso verrà sottoposto a studio e sperimentazione ed i risultati delle specifiche indagini saranno utili per certificare che tale materia prima potrà essere impiegata in ambito parafarmaceutico, cosmetico e per la produzione di dispositivi medici da parte di industrie italiane o estere.
Scopo del progetto è determinare la composizione dell’estratto mucoso di chiocciole d’allevamento in relazione alla loro specie, al sistema d’allevamento, al loro habitat, al tipo di alimentazione e al sistema di estrazione adottato. Questi dati ottenuti porranno le basi per valorizzare e standardizzare una sostanza di scarto (comunemente denominata bava) da utilizzare quale materia prima da destinare in ambito cosmetico, parafarmaceutico e medico per la produzione di diversi prodotti e dispositivi medici in base alle caratteristiche funzionali dell’estratto stesso.